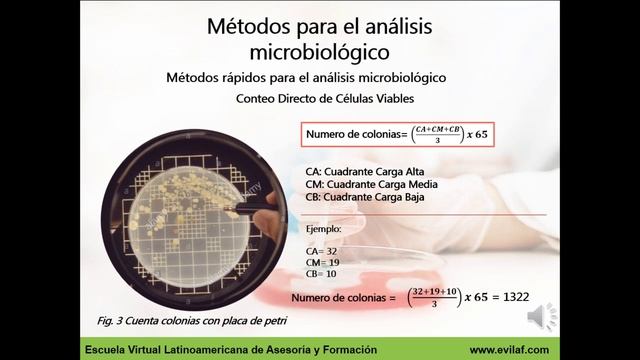
Métodos De Análisis Microbiológicos P2

Похожее видео
×
СУД над каналом Свиньи как Бизнес

Видео: СУД над каналом Свиньи как Бизнес
свиньи как бизнесразоблачениеблогвлогкомаров алексейалексей комаровскбдеревняпоросятасвиньиалтайский крайбарнаулkomlifeкомлайфпетухгорный алтайалтайпосиделкисвиноводческиесвиноводческий консилиумсвиноводческие посиделкиskbkomarovaleksey komarovblogухейилюйприродакомаровживотноводствосвиноводствофермасельское хозяйствосудразборкизаявлениеполициятюрьмазаключениепроблемыуголовное делоуголовный розыск Данное видео является постановочным. все совпадения с реальными людьми случайны!!!,
2026-04-18 в 01:55:19
2025-02-03 в 21:58:13
2026-04-18 в 01:58:14
2026-04-18 в 01:09:40
2025-02-03 в 21:48:43
2026-04-18 в 01:25:46